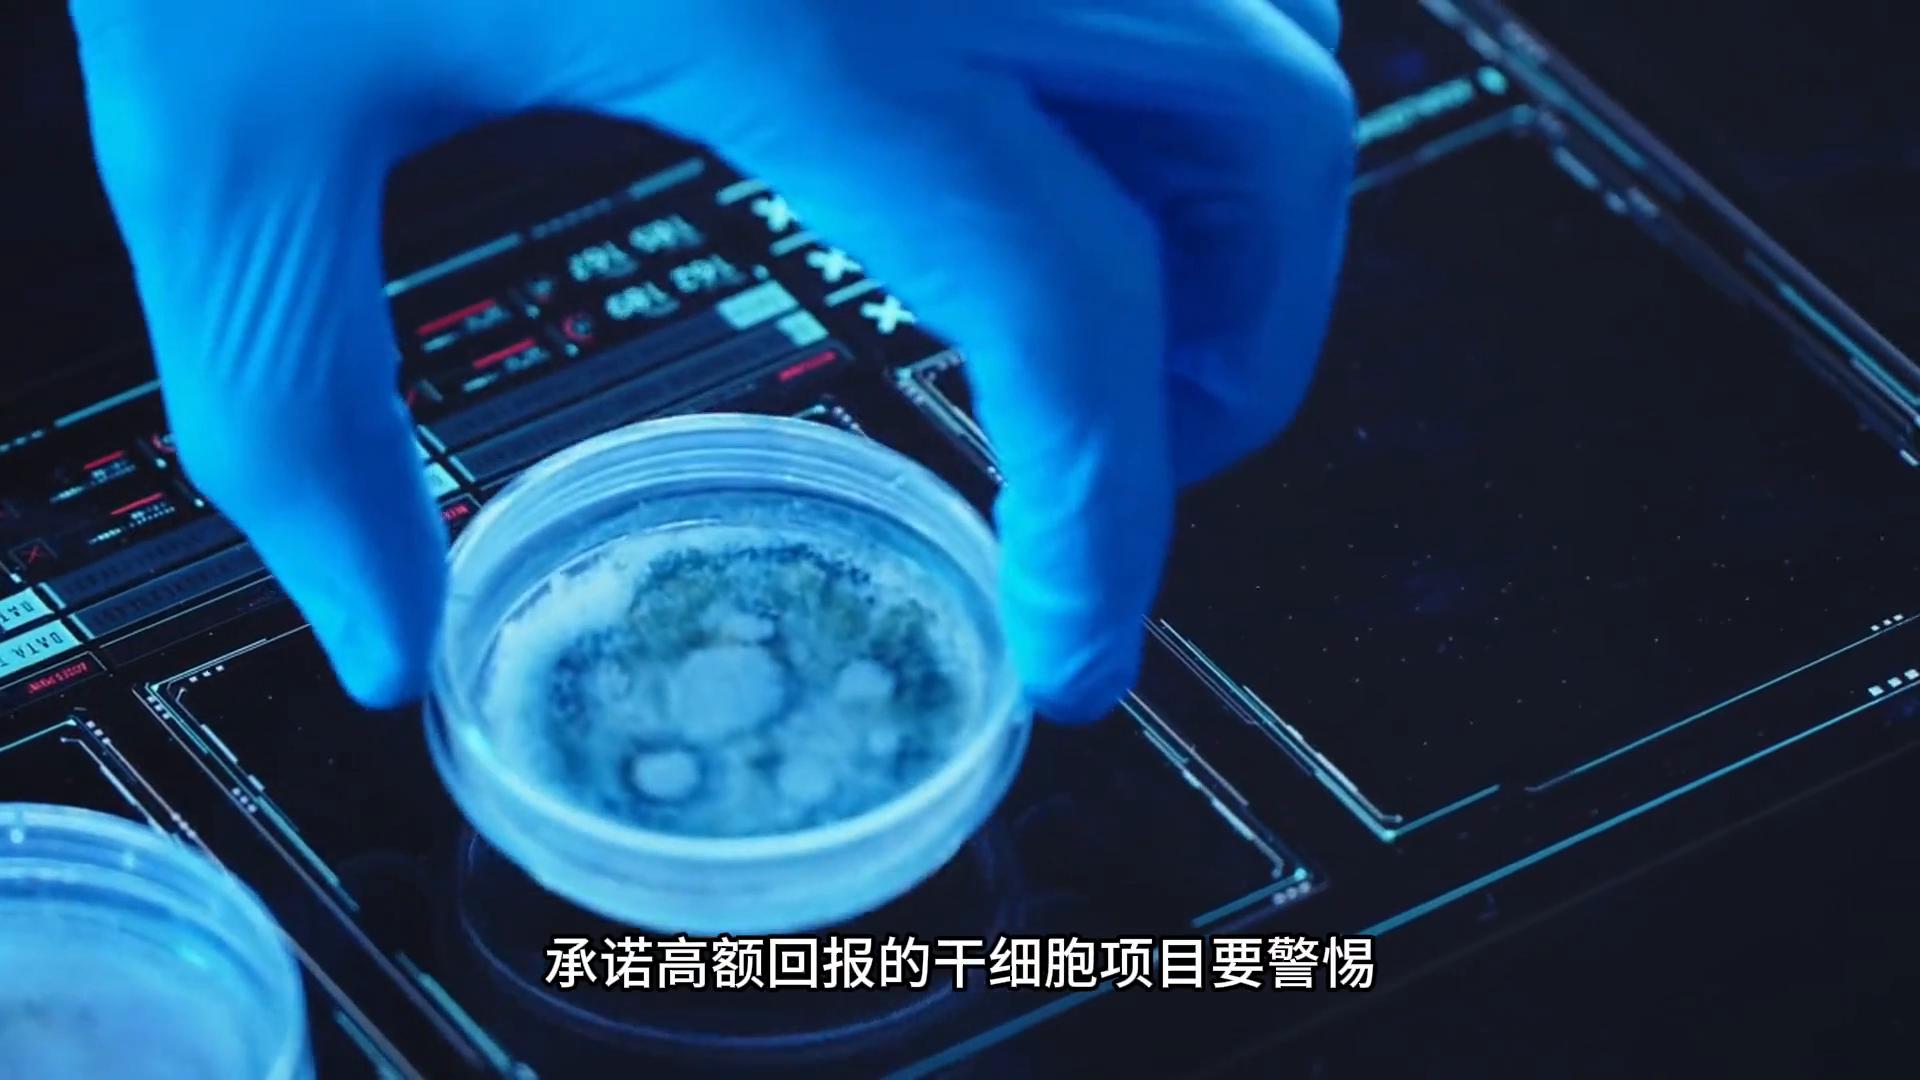
防范干细胞骗局_cctv12揭秘传销_央视曝光干细胞陷阱

警惕!央视曝光“干细胞”陷阱,教你见招拆招!
央视曝光干细胞陷阱,教你见招拆招。
CCTV12社会与法频道曝光了一起惊人的干细胞骗局,引发社会广泛关注。济南市公安局捣毁了一个以干细胞为幌子的传销组织,该团伙3个月领财1.6亿元。利用人们对干细胞知识的盲区和好奇心设下陷阱,这再次为我们敲响了警钟。
在细胞研究和应用火热发展的当下,该如何防范干细胞骗局?筑牢知识防线,识破虚假宣传。干细胞具有自我更新和分化潜能,在医学领域有应用潜力,但目前研究应用尚在发展阶段,并非无所不能。不法分子常夸大其功效,甚至能返老还童。

面对这类没有科学依据的宣传,我们要保持清醒,通过查阅权威学术期刊或关注正规科普平台学习相关知识,增强辨别能力。严选合作机构,远离非法组织。正规机构是保障干细胞研究和应用安全可靠的关键。选择相关项目时,要选有合法资质、信誉良好或经中检院认证的研究机构。这些机构在人员、设备、流程等方面有严格标准和规范。

警惕高额回报,拒绝利益诱惑。天下没有免费的午餐,承诺高额回报的干细胞项目要警惕。不法分子常以投资或巨额回报为幌子,吸引人参与传销、非法集资等活动,让人血本无归。遇到此类项目要保持冷静,勿被利益冲昏头脑。

咨询专业人士,权衡风险利弊。决定进行干细胞项目前,一定要咨询专家或研究机构人员,他们能根据具体情况提供科学建议,帮助了解项目风险和注意事项,评估可行性与安全性。还可咨询相关法律法规政策,保障自身权益。
经过以上四个方面的考虑,你就能避免大部分的干细胞骗局了。作为从事细胞行业的行内人,如果你对干细胞有任何疑问,欢迎共同探讨。
免责声明:由于无法甄别是否为投稿用户创作以及文章的准确性,本站尊重并保护知识产权,根据《信息网络传播权保护条例》,如我们转载的作品侵犯了您的权利,请您通知我们,请将本侵权页面网址发送邮件到qingge@88.com,深感抱歉,我们会做删除处理。




